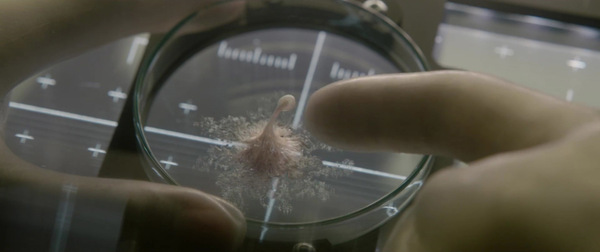

Ода жестокости: обзор фильма «Временные трудности»
Садизм и домашнее насилие под видом истории успеха.
13 сентября на экраны российских кинотеатров вышел фильм «Временные трудности», в котором авторы хотели рассказать вдохновляющую историю силы духа и преодоления. Увы, в последние годы ожидания от подобных картин и так невысоки, мало кто у нас умеет рассказывать действительно «человеческие» истории, не ударяясь в клише. Но на этот раз зрителям показали то, что даже не укладывается в элементарную мораль.
По сюжету в семье упрямого и принципиального работника завода Ивана Ковалёва (Иван Охлобыстин) рождается ребёнок с ДЦП. Но отец решает, что это вовсе не помеха для того, чтобы сын стал таким же, как все. И он с малолетства заставляет ребёнка делать всё самостоятельно, наказывая за любую слабость. Вроде бы жестокая терапия даёт свои плоды, но потом подростка Сашу парализует. Тогда отец отвозит его в лес и заставляет ползти, ведь до дома всего сто километров.
Казалось бы, изначальная идея, которую хотели озвучить в фильме, правильная и даже хорошая. Мальчику Саше говорят, что он такой же, как все. Только на деле садист-отец раз за разом доказывает обратное. Видимо, в понимании тех, кто снимал фильм, «быть нормальным» подразумевает, быть физически здоровым и всё делать самому. И они даже сопровождают идею художественными ассоциациями: отец воспитывает ребёнка, а на заводе в печах выплавляют металлические детали.
По факту же на экране показывают вот что: отец просто издевается над ребёнком, потому что тот не такой, как ему хотелось бы. Плохо ходит — коляску надо сбросить с лестницы, пусть ползёт. Не успел вынести ведро — мусор высыпают ему в кровать, а то и на голову, не может открыть дверь — пусть стоит на улице. Да, ребёнка это закаляет, он учится всё делать сам. Но видимо о таком понятии, как «детская психологическая травма» ни режиссёр, ни сценарист не слышали.
Для того, чтобы Ковалёв-старший выглядел лучше и правильнее, создатели «Временных трудностей» окружают его слабыми и глупыми людьми. Кроме учительницы Саше никто не говорит ободряющих слов, все стыдливо тычут в его болезнь, и только стойкий отец продолжает издеваться над ним во благо.
А дабы зрителю задумываться о морали, постоянно используют два самых простых способа. Во-первых, давят на жалость, делая акцент на трудностях мальчика и его стараниях — кого не зацепят сцены, где ребёнок не может самостоятельно поднять книгу. Во-вторых, давят на ностальгию, и тут уже в ход идут детские песни, пионерские галстуки и лагерь «Артек». Из которого, кстати, Сашу выгоняет подлый чиновник, говорящий, что в СССР инвалидов нельзя показывать иностранцам.
Но всё же не думать о морали невозможно, ведь отца с первых же кадров фильма показали человеком, для которого свои принципы важнее, чем чья-то жизнь — наказывая выпившего работника, он загонял всю бригаду на опасное производство. Так же он поступает и с сыном, и ровно таким же останется до самого финала.
Но даже издевательства над ребёнком не так ужасны, как то, что происходит дальше. После того, как Сашу, который вроде уже почти справился с болезнью, разбивает паралич, отец везёт его в лес. Тут, кстати, некоторые критики не совсем точно подают сюжет — он не бросает сына, а идёт с ним, но ночью тот сам сбегает, прихватив топор. Это, конечно, вовсе не оправдывает поступки Ковалёва-старшего. Тут как раз можно вспомнить о психологических травмах — ведь до чего нужно довести инвалида, чтобы он предпочёл ночью в одиночку ползти по лесу.
И с этого момента картина превращается в настолько дикий фарс, что о нём даже стыдно говорить. Ведь Саша встречает в лесу медведя и от испуга встаёт. То есть ДЦП, как оказывается, это чистая психосоматика. Видимо, раньше он просто недостаточно хотел вылечиться. И видимо все, кто болен этой страшной болезнью, тоже просто недостаточно этого хотят.
Эти события и приводят к тому, что так ярко показывали в трейлерах — Саша становится известным бизнес-тренером, поскольку все проблемы считает «временными трудностями», а потом его приглашают в качестве кризисного управляющего на завод, где теперь руководит его отец.
Уже после премьеры фильма на «Кинотавре» посыпались отзывы и статьи, в которых создателей картины обвиняли в искажении правды о болезнях и даже фашизме. В своё оправдание авторы говорят, что эта история основана на реальных событиях. Действительно, сюжет фильма построен на воспоминаниях бизнес-тренера Аркадия Цукера (хотя тот, почему-то, всё-таки запретил использовать своё имя в сюжете). Но и этот факт выглядит очень слабым аргументом.
Ведь если даже не обращаться к истории жертв психологического насилия, которые часто защищают своих мучителей, фильм вызывает слишком много вопросов. Ни авторы «Временных трудностей» ни сам Цукер, почему-то, не хотят задумываться о том, что было бы, если б герой (хоть реальный, хоть экранный) не встал, не отбился от медведя и не дополз домой. А ответ очень прост — он не смог бы рассказать об этом. И сценаристы взяли бы другую «историю преодоления» о другом ребёнке, победившем болезнь.
Именно так работает «Систематическая ошибка выжившего»: один человек, которому случайно повезло, может рассказать об успехе, а сотни погибших — нет. И пусть не удивляются авторы, что журналисты называют их идеи фашизмом. Ведь от их логики совсем недалеко до рассуждений, что выжившие при победе Гитлера жили бы счастливо. Вот только об этом снимать нельзя, а об издевательствах над инвалидом, почему-то, можно.
И в финале, для тех, кто ещё не понял мораль, всё подаётся даже не в лоб, а просто в глотку. Мать, которую когда-то ребёнку-инвалиду пришлось защищать костылём от нападок отца, заявляет, что эти издевательства — самая сильная любовь, которую она видела в жизни. А как только герой спорит с этим, от него чуть не уходит девушка — внезапно он уже превращается в неблагодарного эгоиста, который не оценил благородных порывов.
На фоне всего этого даже не хочется разбирать само качество фильма. Уже кажется мелочью, что Охлобыстин не меняет интонации уже последние лет пять, что ребёнок, сыгравший юного Сашу, радуется и грустит с одним выражением лица, и что весь антураж выглядит дёшево и карикатурно. Всё это ещё можно простить. А вот саму идею — нет.
Снимать и выпускать такой фильм в нашей стране, где многие инвалиды даже в крупных городах не могут выйти из дома, потому что нет пандусов, съездов с тротуаров и спусков в метро — просто кощунство. Им как будто говорят «у вас временные трудности, хочешь выйти в магазин — ползи по лестнице». Дополз — будет тебе секретарша с длинными ногами и много денег, а если не дополз — сам виноват, видимо плохо старался.
Они как бы противопоставляют две сцены: мальчика-инвалида не пускают в «Артек», и успешный бизнес-консультант ведёт собственный катер. И всё потому, что он смог вылечиться. А если бы не смог — так бы и сидел на шее у матери. И значит отец-садист — настоящий герой, который, преодолевая себя, издевался над сыном ради его будущего.
Ведь авторы то ли не хотят, то ли не могут понять главного — нормальность не оценивается способностью ходить или бегать. Быть не хуже других — не значит обязательно уметь завязывать шнурки самостоятельно. Может стоило в моменте, где Саша становится успешным учеником, сменить направление и показать, что он способен достичь высот в науке? Но нет, лучше романтизировать домашнее насилие.
Когда я шёл в кинотеатр, я уже примерно представлял, что мне покажут на экране. Но говорить что-то о фильме, не посмотрев его лично, было бы просто глупо: за свою жизнь я как минимум дважды шёл в кино с резко негативным настроем, а выходил довольным. Но на этот раз чуда не произошло, стало только хуже.
Я всегда был сторонником идеи «не нравится — не смотри», и искренне не понимал запреты фильмов и петиции за их отмену. Но сегодня в кинотеатре мне впервые в голову закралась мысль: «Я бы хотел, чтобы его запретили». Потому что «Временные трудности» издеваются над всеми людьми, которые живут с неизлечимыми болезнями. И дело не в том, что там героем показан человек, мучивший своего сына. И даже не в том, что какой-нибудь недалёкий родитель после просмотра захочет отвезти своё чадо в лес, чтобы «вылечить». Фильм искажает саму идею «нормальности», показывая прямую связь между излечением физических недугов и успешностью. А это уже действительно опасно.
Источник: https://dtf.ru/cinema/26976-oda-zhestokosti-obzor-filma-vrem...